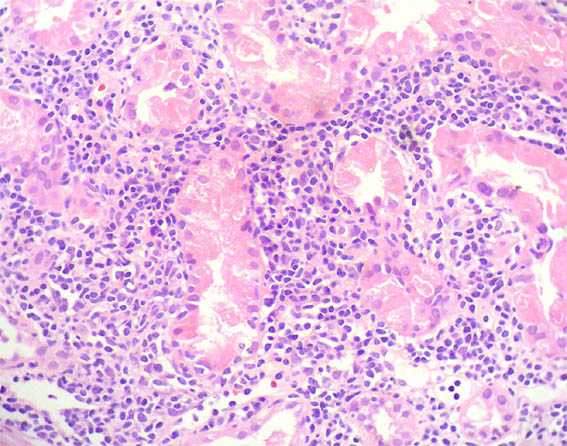

|
|
CASE
133 (March 2017)
Clinical information
The patient is a 59-year-old man with creatinine increased: 2.1 mg/dL (previous 1.0 mg/dL a year earlier). Proteinuria 1.4 g/24h, without hematuria. There is no edema or dyslipidemia. He has had a history of HIV infection for 8 years, on antiretroviral treatment. Hepatitis viruses: negative. Autoimmunity tests: negative. Hemoleukogram: normal. There are no findings suggesting recent infections.
A kidney biopsy was done. See the images.

Figure 1. H&E, X400.

Figure 2. PAS, X400.

Figure 3. H&E, X200.

Figure 4. H&E, X100.

Figure 5. H&E, X200.

Figure 6. H&E, X200.

Figure 7. H&E, X400.
Figure 8. H&E, X400.

Figure 9. PAS, X200.

Figure 10. Methenamine-silver staining, X200.
Direct immunofluorescence for IgA, IgG, IgM, C3, C1q, kappa, and lambda: Negative.
What is your diagnosis?
See
diagnosis and discussion
[Top]
|
|